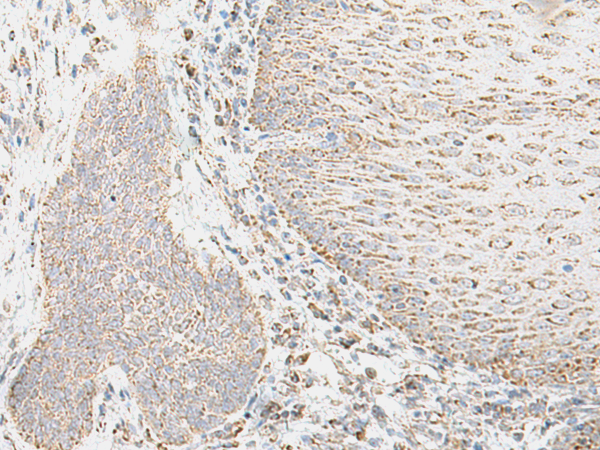

相關(guān)類別: 一抗
克隆類型: rabbit polyclonal
技術(shù)規(guī)格
|
Background: |
This gene encodes a protein that is a member of the integrin superfamily. Members of this family are adhesion receptors that function in signaling from the extracellular matrix to the cell. Integrins are heterodimeric integral membrane proteins composed of an alpha chain and a beta chain. The encoded protein forms a dimer with an alpha v chain and this heterodimer can bind to ligands like fibronectin and transforming growth factor beta 1. Alternate splicing results in multiple transcript variants. |
|
Applications: |
ELISA, IHC |
|
Name of antibody: |
ITGB6 |
|
Immunogen: |
Fusion protein of human ITGB6 |
|
Full name: |
integrin subunit beta 6 |
|
Synonyms: |
AI1H |
|
SwissProt: |
P18564 |
|
ELISA Recommended dilution: |
5000-10000 |
|
IHC positive control: |
Human esophagus cancer and Human thyroid cancer |
|
IHC Recommend dilution: |
50-300 |

購(gòu)物車
幫助
021-54845833/15800441009
